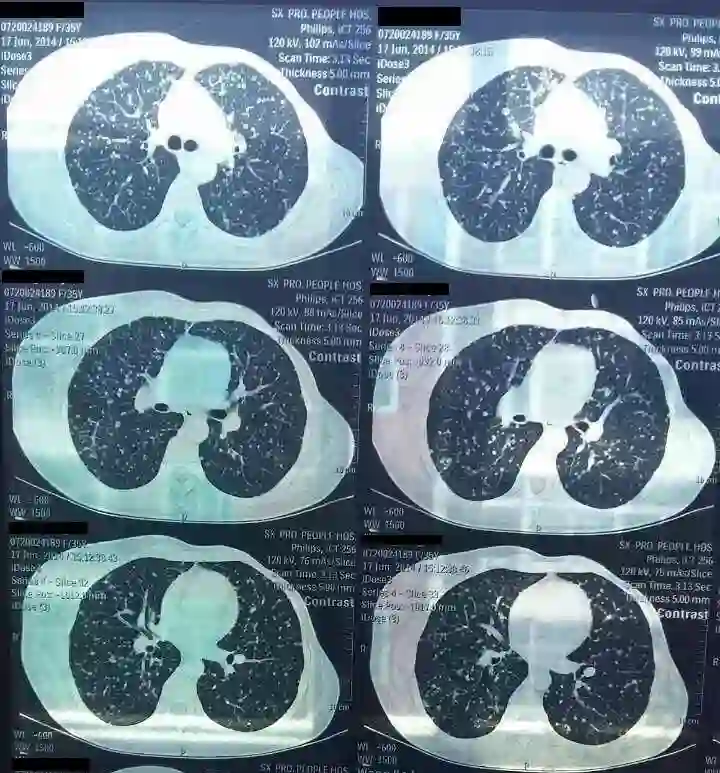

基本情况
美例秀秀|“三阳性”乳腺癌—抗HER2治疗是基础

第34例
HER2阳性型乳腺癌是一种凶险程度很高的乳腺癌亚型,其绝大部分依赖于HER2通路来驱动肿瘤细胞的增殖,与肿瘤侵袭性强、复发率高密切相关。故临床实践中,抗HER2的重要性不言而喻。本文分享的病例为一例HR+/HER2+乳腺癌患者,通过内分泌治疗获得生存获益,但在继发性内分泌治疗耐药后通过积极抗HER2治疗联合内分泌治疗,患者再次获得长期生存获益。
山西省肿瘤医院乳腺二科科室主任
山西医科大学教授、硕士生导师
中国医药教育协会乳腺疾病专业委员会委员
中国医师协会外科医师分会乳腺外科医师委员会委员
山西省医师协会乳腺医师分会会长、肿瘤分会常委
山西省抗癌协会乳腺癌专业委员会委员
山西省肿瘤医院乳腺外科二病区副主任医师
山西省医师协会乳腺医师分会副会长
参与多项国内大规模临床研究,主编专著1部,在各类学术刊物上发表论文多篇。
患者女性,39岁,月经规律。既往体健,否认慢性病、传染病史。2009年12月26日外院诊断为:左乳浸润性导管癌。
诊疗经过
1.手术治疗
患者于2009年12月外院行“左乳癌改良根治术”。术后病理示:左乳浸润性导管癌双灶,大者约20mm,小者约3mm,非特殊类型,SBR Ⅱ级,腋窝淋巴结转移1/11。免疫组化示:ER(+),PR(+),HER2(2+),Ki-67 (<10%),未进一步行FISH检测。术后诊断:左乳腺癌切除术后(pT1N1M0,R0,ⅡA期)。分子分型:HR阳性HER2阳性型。
2.术后辅助治疗
结合患者实际情况,与患者及其家属反复沟通并征得其同意,于术后行EC-T方案(表柔比星+环磷酰胺3周期+多西他赛3周期)6周期治疗,末次化疗时间2010年4月。患者化疗完成后未行放疗,后口服他莫昔芬内分泌治疗至2014年6月。其间定期复查,未见明显复发征象。
2012年2月,患者常规复查时调取手术蜡块行FISH检测提示:HER2扩增。未进一步行抗HER2治疗。
3.复发与治疗
2014年6月,患者因“咳嗽进行性加重1个月”就诊,胸部CT(图1)示:左乳腺癌术后,左侧乳腺未见显示,右侧乳腺腺体内可见多发低密度影及点状高密度钙化影。双肺可见多发大小不等的结节影,结合病史考虑为转移。双侧胸廓对称,纵隔居中,内未见明显肿大淋巴结。
图1 复查胸部CT发现复发(2014年6月)
与患者及其家属反复沟通交流,强调HER2阳性乳腺癌治疗中抗HER2的重要性和必要性,建议行TC+H(紫杉醇+环磷酰胺联合曲妥珠单抗)方案治疗6个周期。在第2、4、6周期进行疗效评价,依次为:轻度缓解(minor regression,MR)、部分缓解(partial response,PR)和完全缓解(complete response,CR)(图2)。化疗结束后于2014年11月起至2017年5月行内分泌联合抗HER2治疗,具体用药为:戈舍瑞林+依西美坦联合曲妥珠单抗。
图2 患者化疗后复查胸部CT(左图2014-09,右图2014-12)
2017年5月复查头颅MRI时提示脑转移(图3),于6月起行脑转移瘤局部6MV-X线外照射调强放疗(共计95%PGTV 60.0 Gy/25次/33天, 95%PTV 40.0 Gy/25次/26天, 95%PGTV 50.0 Gy/25次/33天),转移灶病变有所缓解。于2017年9月起行二线内分泌联合抗HER2治疗,具体治疗方案为:戈舍瑞林+氟维司群同时联合曲妥珠单抗至今,未见明显其他复发和转移征象(图4)。
图3 头颅MRI提示脑转移(2017年5月)
图4 头颅MRI(2018年7月)
总结
患者于2009年12月行左乳癌改良根治术,术后病理示:左乳浸润性导管癌,腋窝淋巴结转移1/17枚。免疫组化示:ER(+),PR(+),HER2(2+),Ki-67 (<10%),后补做FISH提示HER2扩增。术后诊断:左乳腺癌切除术后(pT1N1M0,R0,ⅡA期),分子分型:HR阳性HER2阳性型。术后6周期EC-T方案化疗后口服他莫昔芬近4年。2014年6月复查发现肺转移灶,行TC+H方案治疗6周期,后续行戈舍瑞林+依西美坦联合曲妥珠单抗维持治疗治疗。2017年5月发现脑转移行局部放疗后内分泌二线戈舍瑞林+氟维司群同时联合曲妥珠单抗维持治疗至今,定期复查,未见疾病明显其他复发或者进展(图5)。
图5 患者治疗历程图
点评专家
湖南省肿瘤医院乳腺内科主任
中国抗癌协会乳腺癌专业委员会委员
中国临床肿瘤学会乳腺癌专家委员会委员
中国医药教育协会乳腺疾病专业委员会常委
中国研究型医院学会乳腺专业委员会常务委员、精准医学与肿瘤MDT专业委员会乳腺学组副组长
湖南省医学会肿瘤内科学专业委员会主任委员、肿瘤化疗专业委员会乳腺癌学组组长
湖南省妇幼保健与优生优育协会妇科与乳腺肿瘤防治专业委员会主任委员
湖南省抗癌协会肿瘤化疗专业委员会副主任委员
湖南省肿瘤医院乳腺内科
中国抗癌协会会员
湖南省肿瘤医院乳腺癌多学科诊疗团队成员
湖南省妇幼保健与优生优育协会妇科与乳腺肿瘤防治专业委员会委员
湖南省抗癌协会分子靶向治疗专业委员会委员
湖南省健康管理学会乳腺甲状腺健康管理专业委员会副主任委员
湖南省预防医学会乳腺疾病防治专业委员会常委
湖南省肿瘤医院 乳腺内科
点评
患者为年轻女性,发病时29岁,术后分期:pT1N1M0,ⅡA期(HR阳性,HER2++,未行FISH检测,HER2状态未明,当时不能确诊为HR阳性HER2阳性乳腺癌),根据NCCN指南推荐,HER2++患者,必须明确HER2状态,若HER2阳性,优选辅助治疗方案是AC-TH或TCbH,APHINITY研究[1]结果显示,与曲妥珠单抗单靶治疗相比,帕妥珠单抗和曲妥珠单抗双靶治疗方案能够降低 19% 的无侵袭生存(invasive disease free survival, iDFS) 事件(HR=0.81;95%CI 0.66~1.00;P=0.045),其中淋巴结阳性患者和激素受体阴性患者从治疗中获益最多。对于有高危复发风险的患者,可考虑给予帕妥珠单抗和曲妥珠单抗双靶向辅助治疗。该例患者术后6周期(EC×3-T×3)并不是标准的辅助化疗方案。无论是疗程还是药物的累计剂量,均未达到标准剂量,并且患者术后未及时行FISH检测,导致辅助靶向治疗缺失,影响患者预后。术后2年检测HER2阳性,根据HERA研究[2],HER2阳性乳腺癌术后延迟使用曲妥珠单抗仍然能从辅助抗HER2治疗中获益,因此,患者术后2年FISH检测提示HER2阳性,应该使用曲妥珠单抗辅助靶向治疗1年。化疗后未行放疗,对于年轻、合并淋巴结转移的HER2阳性乳腺癌患者,术后应行辅助放疗,以降低局部及远处复发风险,该患者化疗后未行放疗;患者为年轻乳腺癌,虽然只有1枚腋窝淋巴结转移,但是HR阳性、HER2阳性,仍然具有高危复发风险,辅助内分泌治疗建议在抗HER2治疗基础上,联合卵巢功能抑制(ovarian function suppression,OFS)+芳香化酶抑制剂(AI),单用他莫昔芬是不够的。以上辅助治疗的不规范可能是患者复发的一个重要原因。
患者2014年出现双肺转移,对于HR阳性、HER2阳性晚期乳腺癌患者的一线治疗,国内外指南均推荐应优先考虑靶向治疗联合化疗。一线治疗的方案选择,根据NCCN指南推荐,首选帕妥珠单抗+曲妥珠单抗+紫杉类(CLEOPATRA)[3],但由于帕妥珠单抗的不可获得性,目前CSCO指南Ⅰ级推荐一线给予含紫杉类的TXH方案或NH方案,Ⅱ级和Ⅲ级推荐的方案有TH、THP、XH、TCbH等,TC(4)H虽为含紫杉类方案,但在转移性乳腺癌的治疗中缺乏循证医学证据支持。HR阳性、HER2阳性晚期乳腺癌患者在一线化疗联合靶向治疗获得缓解后,改为靶向联合内分泌维持治疗,符合全程管理原则,OFS+AI+H的方案选择也符合目前的循证医学证据。患者2017年出现多发脑转移,基于ASCO、CSCO指南推荐,HER2阳性晚期乳腺癌治疗过程中出现脑转移,如果颅外病灶未进展,经有效的脑转移灶局部治疗后,可考虑继续使用原方案治疗。该患者内分泌治疗期间颅外病灶稳定,出现脑转移,脑部病灶放疗后保留曲妥珠单抗、更换内分泌治疗仍然获益,这是值得肯定的。
从该例患者的治疗中带给我们一些思考:①对于术后病理HER2++的患者,强调FISH检测的重要性,明确HER2状态,这不仅是利于预后的判断,更重要的是HER2状态的判断影响辅助治疗方案的制定。对于HER2阳性早期乳腺癌,抗HER2治疗是否规范对预后有重要的影响;而对于高危复发风险的患者,还可以考虑给予帕妥珠单抗和曲妥珠单抗双靶向辅助治疗,进一步降低复发风险。②复发转移的HR阳性/HER2阳性乳腺癌,持续抗HER2治疗仍然是关键,在靶向联合化疗有效的情况下,改为靶向联合内分泌维持治疗,一方面患者从持续抗HER2治疗中获益,另一方面治疗耐受性好,可维持患者良好的生活质量。③HER2阳性晚期乳腺癌治疗过程中出现脑转移,如果颅外病灶未进展,经有效的脑转移灶局部治疗后,可考虑继续使用原方案治疗。但在临床实践中,需要根据患者具体情况制订个体化治疗方案,还需要更多的研究去探索不同治疗方案的获益人群。
1.MINCKWITZ G, PROCTER M, AZAMBUJA E, et al. APHINITY Steering Committee and Investigators. Adjuvant pertuzumab and trastuzumab in early HER2-positive breast cancer[J]. N Engl J Med,2017 ,377(2):122-131.
2.CAMERON D, PICCART-GEBHART M J, GELBER R D, et al. 11 years' follow-up of trastuzumab after adjuvant chemotherapy in HER2-positive early breast cancer: final analysis of the HERceptin Adjuvant (HERA) trial[J]. Lancet,2017,389(10075):1195-1205.
3.MILES D, IM Y H, FUNG A, et al. Effect of docetaxel duration on clinical outcomes: Exploratory analysis of CLEOPATRA, a phase III randomized controlled trial[J]. Ann Oncol,2017,28(11):2761-2767.
41本肿瘤患者指南丛书
点击下方图片即可免费阅读
70个肿瘤相关临床试验招募患者
点击下方图片或识别图片二维码即可查看详情